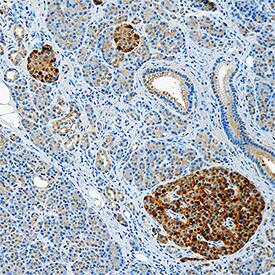
IL-18/IL-1F4 antibody in Human Pancreas by Immunohistochemistry (IHC-P).

Human IL-18/IL-1F4 Antibody
R&D Systems, part of Bio-Techne | Catalog # MAB91245


Conjugate
Catalog #
Key Product Details
Species Reactivity
Human
Applications
Immunohistochemistry
Label
Unconjugated
Antibody Source
Monoclonal Mouse IgG1 Clone # 923503
Product Specifications
Immunogen
E. coli-derived recombinant human IL-18/IL-1F4
Tyr37-Asp193
Accession # Q14116
Tyr37-Asp193
Accession # Q14116
Specificity
Detects human IL-18/IL-1F4 in direct ELISAs.
Clonality
Monoclonal
Host
Mouse
Isotype
IgG1
Scientific Data Images for Human IL-18/IL-1F4 Antibody
IL‑18/IL‑1F4 in Human Spleen.
IL-18/IL-1F4 was detected in immersion fixed paraffin-embedded sections of human spleen using Mouse Anti-Human IL-18/IL-1F4 Monoclonal Antibody (Catalog # MAB91245) at 15 µg/mL for 1 hour at room temperature followed by incubation with the Anti-Mouse IgG VisUCyte™ HRP Polymer Antibody (Catalog # VC001). Before incubation with the primary antibody, tissue was subjected to heat-induced epitope retrieval using Antigen Retrieval Reagent-Basic (Catalog # CTS013). Tissue was stained using DAB (brown) and counterstained with hematoxylin (blue). Specific staining was localized to T cells. View our protocol for IHC Staining with VisUCyte HRP Polymer Detection Reagents.IL‑18/IL‑1F4 in Human Pancreas.
IL-18/IL-1F4 was detected in immersion fixed paraffin-embedded sections of human pancreas using Mouse Anti-Human IL-18/IL-1F4 Monoclonal Antibody (Catalog # MAB91245) at 5 µg/mL for 1 hour at room temperature followed by incubation with the Anti-Mouse IgG VisUCyte™ HRP Polymer Antibody (Catalog # VC001). Before incubation with the primary antibody, tissue was subjected to heat-induced epitope retrieval using Antigen Retrieval Reagent-Basic (Catalog # CTS013). Tissue was stained using DAB (brown) and counterstained with hematoxylin (blue). Specific staining was localized to cytoplasm in islet cells. View our protocol for IHC Staining with VisUCyte HRP Polymer Detection Reagents.Applications for Human IL-18/IL-1F4 Antibody
Application
Recommended Usage
Immunohistochemistry
5-25 µg/mL
Sample: Immersion fixed paraffin-embedded sections of human spleen and human pancreas
Sample: Immersion fixed paraffin-embedded sections of human spleen and human pancreas
Formulation, Preparation, and Storage
Purification
Protein A or G purified from cell culture supernatant
Reconstitution
Reconstitute at 0.5 mg/mL in sterile PBS. For liquid material, refer to CoA for concentration.
Formulation
Lyophilized from a 0.2 μm filtered solution in PBS with Trehalose. *Small pack size (SP) is supplied either lyophilized or as a 0.2 µm filtered solution in PBS.
Shipping
Lyophilized product is shipped at ambient temperature. Liquid small pack size (-SP) is shipped with polar packs. Upon receipt, store immediately at the temperature recommended below.
Stability & Storage
Use a manual defrost freezer and avoid repeated freeze-thaw cycles.
- 12 months from date of receipt, -20 to -70 °C as supplied.
- 1 month, 2 to 8 °C under sterile conditions after reconstitution.
- 6 months, -20 to -70 °C under sterile conditions after reconstitution.
Background: IL-18/IL-1F4
IL-18 activation is induced by infection or tissue damage and contributes to disease pathology in chronic inflammation (1-3). IL-18 binds to the widely expressed
IL-18 R alpha which recruits IL-18 R beta to form the signaling receptor complex (4, 5). Its bioactivity is negatively regulated by interactions with IL-18 binding proteins and virally encoded IL-18BP homologs (6). In the presence of IL-12 or IL-15, IL-18 enhances anti-viral Th1 immune responses by inducing IFN-gamma production and the cytolytic activity of CD8+ T cells and NK cells (7, 8). In the absence of IL-12 or IL-15, however, IL-18 promotes production of the Th2 cytokines IL-4 and IL-13 by CD4+ T cells and basophils (9, 10). In the presence of IL-1 beta or IL-23, IL-18 induces the antigen-independent production of IL-17 by gamma delta T cells and CD4+ T cells (11).
IL-18 also promotes myeloid dendritic cell maturation and triggers neutrophil respiratory burst (12, 13). In cancer, IL-18 exhibits diverse activities including enhancing anti-tumor immunity, inhibiting or promoting angiogenesis, and promoting tumor cell metastasis (14). Mature human IL-18 shares approximately 63% amino acid sequence identity with mouse and rat IL-18 (15). Alternative splicing in human ovarian cancer generates an isoform that is resistant to Caspase-1 activation (16). A cell surface form can be expressed on M-CSF induced macrophages and released in response to bacterial endotoxin (17).
References
- Dinarello, C.A. et al. (2013) Front. Immunol. 4:289.
- Smith, D.E. (2011) J. Leukoc. Biol. 89:383.
- Gu, Y. et al. (1997) Science 275:206.
- Torigoe, K. et al. (1997) J. Biol. Chem. 272:25737.
- Cheung, H. et al. (2005) J. Immunol. 174:5351.
- Novick, D. et al. (1999) Immunity 10:127.
- Fehniger, T.A. et al. (1999) J. Immunol. 162:4511.
- Yoshimoto, T. et al. (1998) J. Immunol. 161:3400.
- Yoshimoto, T. et al. (2000) Nat. Immunol. 1:132.
- Kroeger, K.M. et al. (2009) J. Leukoc. Biol. 86:769.
- Lalor, S.J. et al. (2011) J. Immunol. 186:5738.
- Li, J. et al. (2004) Cell. Immunol. 227:103.
- Elbim, C. et al. (2005) Clin. Diagn. Lab. Immunol. 12:436.
- Fabbi, M. et al. (2015) J. Leukoc. Biol. 97:665.
- Ushio, S. et al. (1996) J. Immunol. 156:4274.
- Gaggero, A. et al. (2004) Oncogene 23:7552.
- Bellora, F. et al. (2012) Eur. J. Immunol. 42:1618.
Long Name
Interleukin 18
Alternate Names
IGIF, IL-1F4, IL-1g, IL18
Gene Symbol
IL18
UniProt
Additional IL-18/IL-1F4 Products
Product Documents for Human IL-18/IL-1F4 Antibody
Product Specific Notices for Human IL-18/IL-1F4 Antibody
For research use only
Loading...
Loading...
Loading...
Loading...